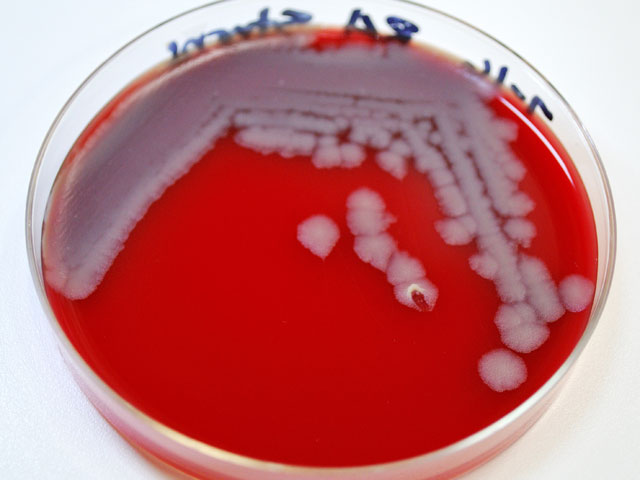

Сибирская язва в Алтайском крае: один человек умер, трое госпитализированы
Четыре человека заразились сибирской язвой в Алтайском крае, один скончался. Меры по борьбе с сибирской язвой предпринимаются в селе Дружба Целинного района Алтайского края, передает "Интерфакс".
В Целинном районе введен режим чрезвычайной ситуации. "На месте ЧС работают оперативные группы администрации района, Главного управления МЧС России по Алтайскому краю, территориального отделения Управления Роспотребнадзора по Алтайскому краю в Бийске, краевого центра медицины катастроф, отдела полиции по Целинному району", - сообщили в МЧС.
Источником заражения, возможно, послужила павшая у одного из жителей корова. "Причиной того, что одного человека медикам спасти не удалось, стало то, что он слишком поздно, только через неделю, обратился за медицинской помощью", - сказали в краевой администрации.